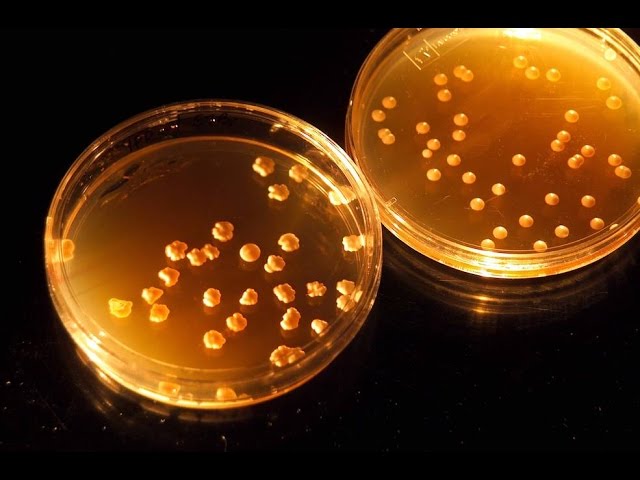

Channel / Source:
The David Pakman Show
Published: 2015-08-21
Source: https://www.youtube.com/watch?v=ffEEqQsycdE